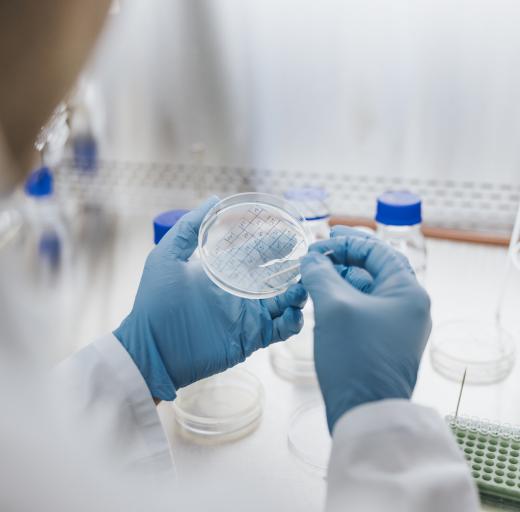
laboratorium kweekschaal stamcel onderzoek

Eiwit helpt longweefsel herstellen bij COPD
Tijdens zijn promotieonderzoek aan de Rijksuniversiteit Groningen deed dr. Luke van der Koog een bijzondere ontdekking: hij zag dat een bepaald eiwit de groei van cellen in zogeheten mini-longetjes stimuleert. Hoe kan deze ontdekking leiden tot het eerste medicijn dat het longweefsel bij COPD herstelt? Dat legt hij uit.
COPD
Wereldwijd is COPD de vierde doodsoorzaak. In Nederland hebben zo’n 550.000 mensen deze longziekte. Bij hen zijn de longblaasjes blijvend beschadigd, waardoor ademen steeds moeilijker wordt. Veel patiënten zijn snel benauwd en hoesten veel. Dr. Luke van der Koog van de Rijksuniversiteit Groningen deed promotieonderzoek naar de invloed van verschillende soorten eiwitten op de long-stamcellen van muizen en mensen met COPD.
Testen op de mini-long
Voor zijn onderzoek gebruikte Luke van der Koog zogenoemde mini-longetjes, oftewel longorganoïden. Dat zijn kleine stukjes longweefsel die in het laboratorium worden gekweekt uit stamcellen van muizen of mensen. In zo’n mini-long reageren de stamcellen op prikkels uit hun omgeving, net als in een echte long. ‘Wanneer we deze mini-longetjes blootstellen aan schadelijke stoffen, zoals sigarettenrook of luchtvervuiling, zien we dat er minder nieuwe mini-longetjes ontstaan,’ vertelt van der Koog. ‘Dat laat goed zien wat er misgaat bij mensen met COPD: de herstellende cellen raken uitgeput en het longweefsel kan zich niet meer goed vernieuwen.’ Tijdens het onderzoek ontdekte hij echter dat één specifiek eiwit, Osteoglycine genaamd, dit herstel juist kan stimuleren. ‘Als we Osteoglycine toevoegden aan de mini-longetjes, zagen we dat er meer mini-longetjes ontstonden. Zelfs wanneer we ze blootstelden aan sigarettenrook bleef dat positieve effect zichtbaar,’ zegt hij. ‘Dat betekent dat Osteoglycine de stamcellen helpt om te blijven groeien en het longweefsel mogelijk kan herstellen.’ Daarna testte hij dit ook in mini-longetjes die waren gemaakt uit longweefsel van mensen met COPD. ‘Ook daar zagen we dat het toevoegen van Osteoglycine de groei en herstel verbeterde. Dat maakt het een veelbelovende ontdekking voor de ontwikkeling van nieuwe behandelingen.

‘Het eiwit wordt verwerkt tot een fijn poeder dat met een inhalator kan worden ingeademd. Zo komt het geneesmiddel precies op de plek waar het nodig is.'
Van lab naar patiënt
De Rijksuniversiteit Groningen heeft inmiddels de behandeling met dit eiwit laten patenteren. Daarmee is vastgelegd dat niemand anders voor een bepaalde tijd het middel mag namaken of verkopen zonder toestemming. Van der Koog legt uit: ‘Het eiwit zelf kun je niet patenteren, omdat het van nature in het lichaam voorkomt. Maar de behandeling die we ermee ontwikkelen, dat kan wél.’ Om het middel verder te ontwikkelen tot een echt geneesmiddel, richtten de onderzoekers het bedrijf MimeCure op, waarvan Van der Koog mededirecteur is. ‘Het is een heel leerzaam proces,’ vertelt hij. ‘Als onderzoeker denk je vooral aan experimenten, maar in een bedrijf kijk je breder: hoe kun je iets daadwerkelijk bij de patiënt krijgen? Ik sta niet meer zelf in het lab, maar ik denk nog steeds actief mee over wat er onderzocht moet worden en hoe we dat zo snel mogelijk kunnen vertalen naar de kliniek.’
Vervolgonderzoek
De grote vraag is natuurlijk: wanneer komt er een geneesmiddel tegen COPD op de markt? ‘We doen nu de laatste testen om te laten zien dat het middel echt werkt en het verloop van de ziekte kan remmen,’ vertelt Van der Koog. ‘Daarna volgen veiligheidsstudies, eerst bij dieren en later bij mensen. Dat zal op zijn vroegst in 2028 zijn. Als alles goed gaat, zou het middel in 2032 of 2033 beschikbaar kunnen zijn.’
Toediening
Omdat COPD een longaandoening is, richt het onderzoek zich op rechtstreekse toediening in de longen. ‘Het eiwit wordt verwerkt tot een fijn poeder dat met een inhalator kan worden ingeademd,’ legt Van der Koog uit. ‘Zo komt het geneesmiddel precies op de plek waar het nodig is. Daardoor kun je het lokaal hogere doseringen geven, zonder dat er veel bijwerkingen optreden.’
Steun van Longfonds
Bij MimeCure werken ervaren onderzoekers uit verschillende vakgebieden samen. Het ontwikkelen van een nieuw medicijn duurt gemiddeld tien tot twaalf jaar en kost veel geld. Longfonds kende aan dit onderzoek de PPS-toeslag toe, een bedrag van 365.000 euro. Dit bedrag is beschikbaar gesteld door de Topsector Life Sciences & Health aan Longfonds, en is bedoeld om samenwerking tussen universiteiten en bedrijven te stimuleren. MimeCure is inmiddels bezig met een nieuwe financieringsronde om het onderzoek verder te brengen.
Tekst: Judith Langeland